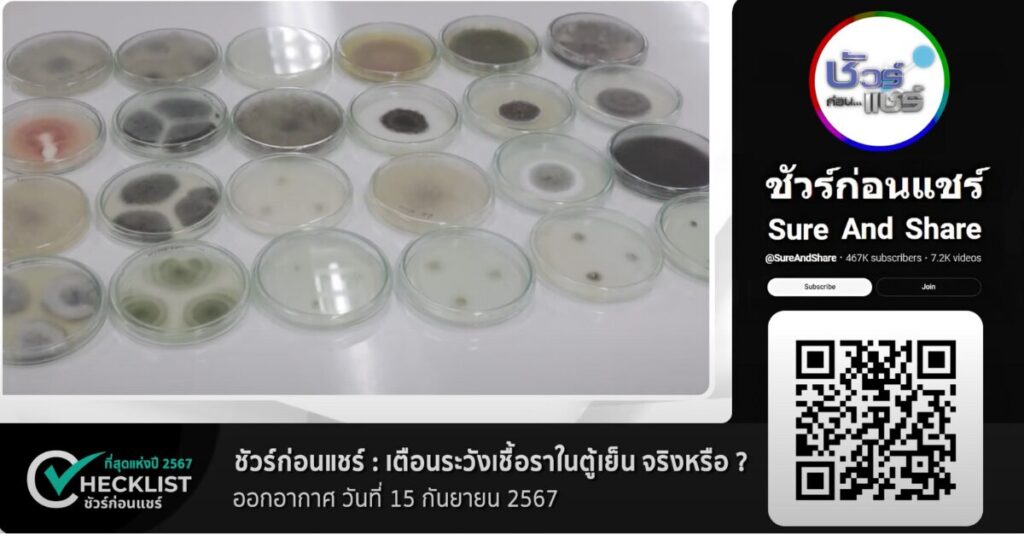

18 ธันวาคม 2567 – เข้าสู่เทศกาลส่งท้ายปี 2567 ชัวร์ก่อนแชร์ขอรวมคลิปที่สุดแห่งปี ที่มียอดผู้รับชมสูงสุดบนแพลตฟอร์ม YouTube ของเรามาฝากกันค่ะ
ชัวร์ก่อนแชร์ รวบรวมคลิปยอดฮิตประจำปี 2567 ที่มียอดผู้ชมสูงสุดบน YouTube 3 อันดับ ได้แก่
1. ติดยาดมอันตราย จริงหรือ ?
ตรวจสอบกับ แพทย์แผนไทยคมสัน ทินกร ณ อยุธยา รองคณบดีวิทยาลัยแพทย์ตะวันออก มหาวิทยาลัยรังสิต
บทสรุป : จริง แชร์ได้ ✅
: การติดยาดมเป็นอันตรายจริง เพราะในยาดมมีสารต่าง ๆ เช่น เมนทอล และการบูร ที่ส่งผลต่อระบบทางเดินหายใจและสมอง การใช้บ่อย ๆ อาจทำให้เกิดการเสพติดและเป็นอันตรายต่อปอดได้ ควรใช้ยาดมเฉพาะเมื่อมีอาการเท่านั้น

2. กินไข่คนมะเขือเทศดิบอันตราย จริงหรือ ?
บทสรุป : แชร์ได้ อธิบายเพิ่ม ⚠️
ตรวจสอบกับ ผศ.ดร.จุติภรณ์ ทัสสกุลพนิช ภาควิชาพืชสวน คณะเกษตร มหาวิทยาลัยเกษตรศาสตร์
: ไข่คนมะเขือเทศดิบ มีสารพิษชื่อ โซลานีน แต่มีปริมาณน้อยมากในมะเขือเทศสุกที่เรากินกันทั่วไป และสารนี้จะสลายไปเมื่อโดนความร้อน ดังนั้นจึงไม่ต้องกังวลเรื่องอันตรายจากการกินไข่คนมะเขือเทศดิบ

3. เตือน‼️ ระวังเชื้อราในตู้เย็น จริงหรือ ?
บทสรุป : จริง แชร์ได้ ✅
ตรวจสอบกับ รศ.ดร.อรอุมา เพียซ้าย ภาควิชาโรคพืช คณะเกษตร มหาวิทยาลัยเกษตรศาสตร์ กรรมการสมาคมสารพิษจากเชื้อราแห่งประเทศไทย
:ในตู้เย็นมีเชื้อราได้จริง โดยเฉพาะเชื้อรา Aspergillus ซึ่งเจริญเติบโตได้ดีในที่ชื้นและอุณหภูมิต่ำ แนะนำให้ล้างทำความสะอาดตู้เย็นเป็นประจำ เก็บอาหารในภาชนะปิดมิดชิด และไม่ปล่อยให้อาหารเน่าเสียในตู้เย็น
ตรวจสอบข้อมูลก่อนแชร์ เพื่อป้องกันการเผยแพร่ข้อมูลที่ผิดนะคะ
ตรวจสอบข้อเท็จจริงโดย : พีรพล อนุตรโสตถิ์
เรียบเรียงโดย : ชยานิษฐ์ ผ่องใส
หากได้รับอะไรมา อย่าเพิ่งแชร์ต่อ ส่งมาตรวจสอบกับ “ศูนย์ชัวร์ก่อนแชร์”
LINE :: @SureAndShare หรือคลิก http://line.sure.guru
FB :: https://www.facebook.com/SureAndShare
YouTube :: https://www.youtube.com/@SureAndShare
Twitter :: https://www.twitter.com/SureAndShare
IG :: https://instagram.com/SureAndShare
Website :: http://www.ชัวร์ก่อนแชร์.com
TikTok :: https://www.tiktok.com/@sureandshare
สมัครรับฟรี ชัวร์ก่อนแชร์ Newsletter ส่งถึงกล่องอีเมลของคุณทุกสัปดาห์ :: https://i.sure.guru/sureandshareNewsletter